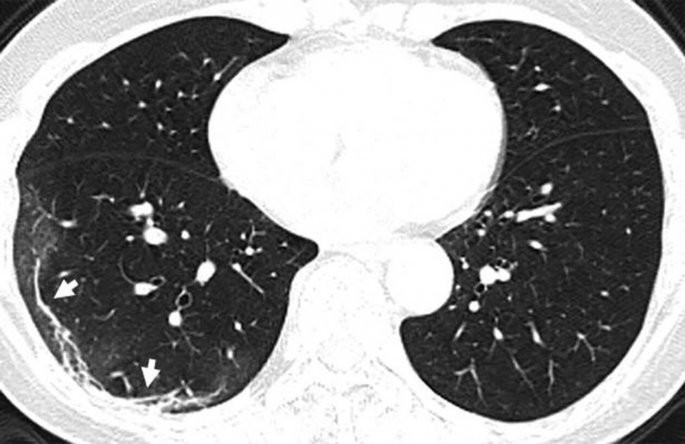
koronoios-4.jpg

Κορωνοϊός: Ανατριχιαστική ακτινογραφία ασθενούς
Διαβάστε σχετικά
- Κορονοϊός και εμβόλιο: Πού βρισκόμαστε σήμερα - Έρευνες ανά τον κόσμο
- Έκκληση για αίμα από το Εθνικό Κέντρο Αιμοδοσίας
- Κορωνοϊός: Άλλοι 189 θάνατοι σε μία μόνο ημέρα στην Ιταλία
- 18 νέα κρούσματα κορωνοιού στην Ελλάδα!
- Στην 25η θέση παγκοσμίως η Ελλάδα στα κρούσματα κορωνοϊού